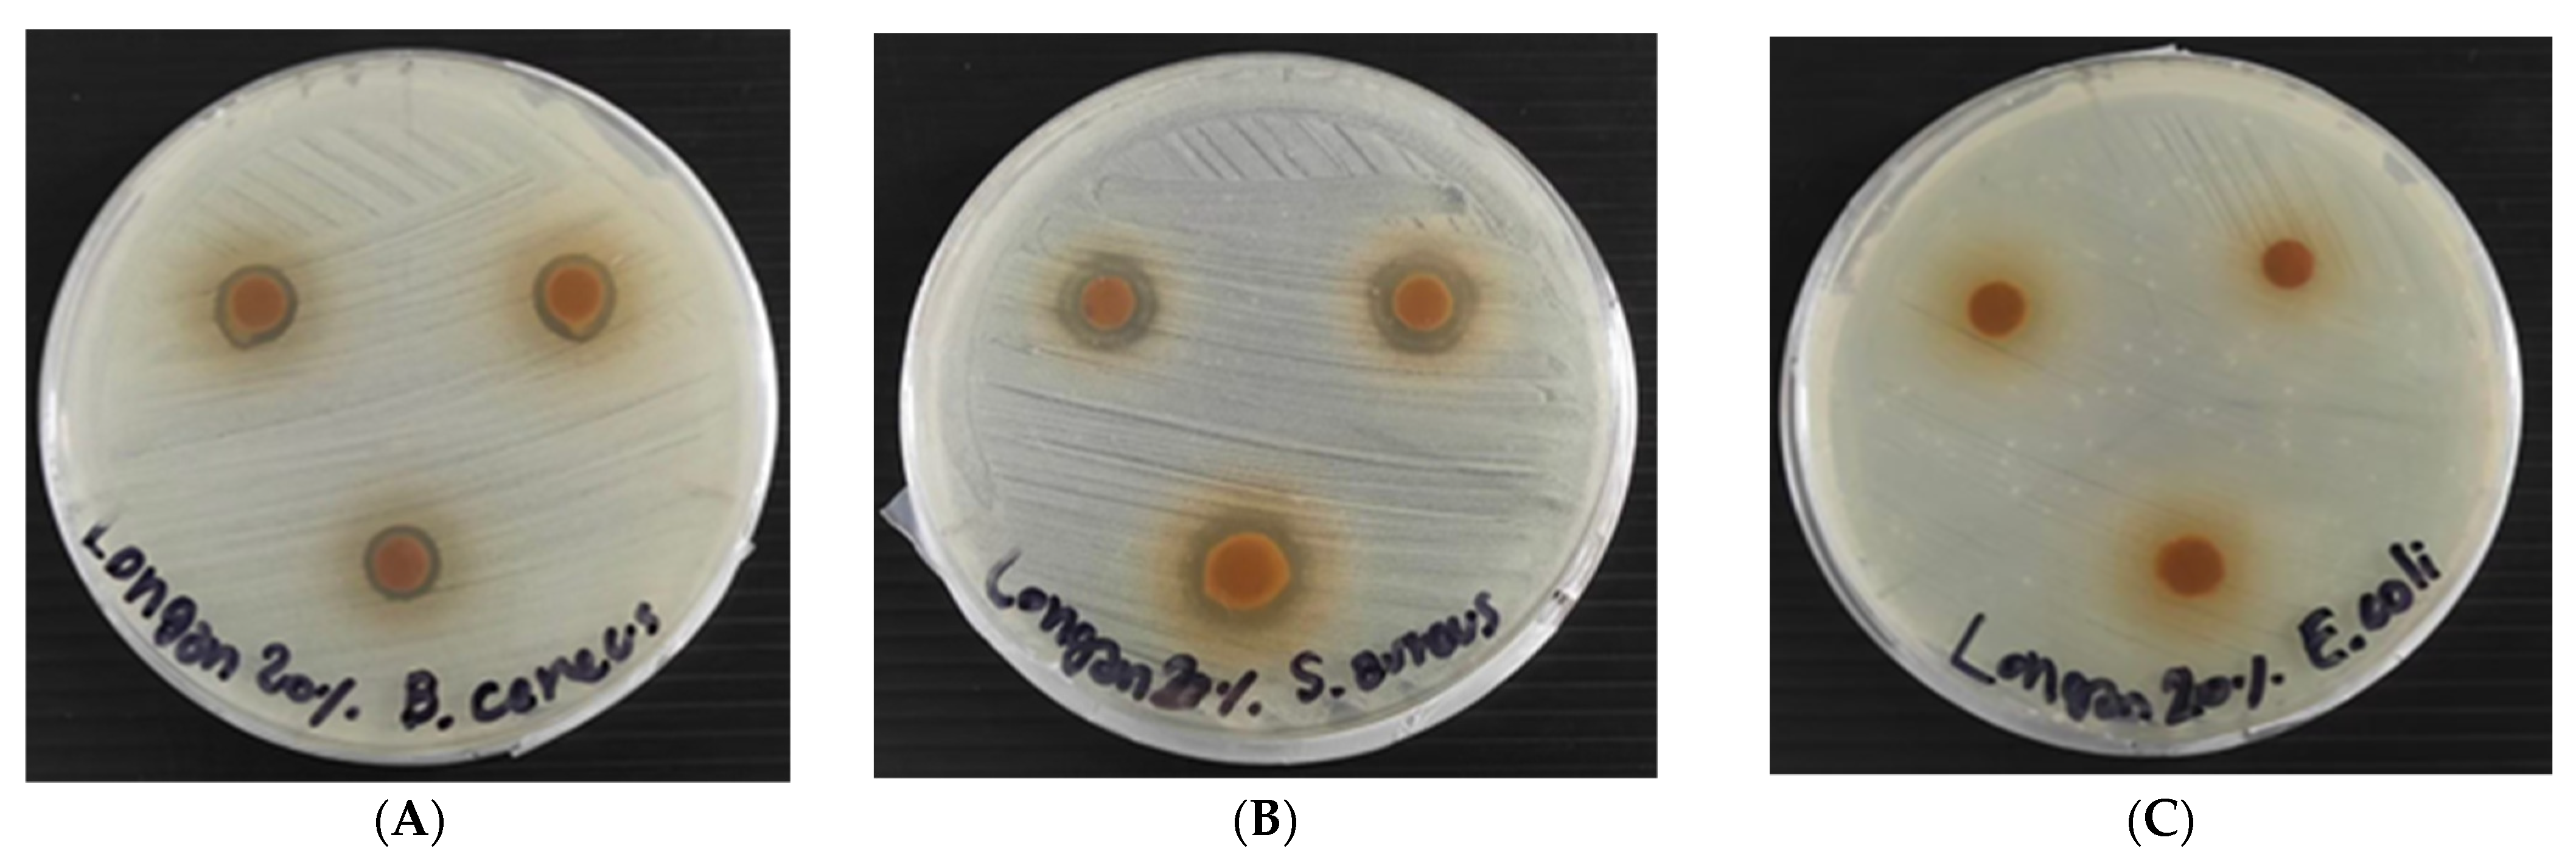

Eco-Friendly Rice Straw Paper Coated with Longan (Dimocarpus longan) Peel Extract as Bio-Based and Antibacterial Packaging
Abstract
:1. Introduction
2. Materials and Methods
2.1. Materials
2.2. Extraction of Longan Peels
2.3. Total Phenolic Content Determination
2.4. High Performance Liquid Chromatography (HPLC) Analysis of Longan Peel Extract
2.5. Preparation of Rice Straw Paper (RSP)
2.6. Preparation of Coated Longan Peel Extract Papers (Coated RSP)
2.7. Characterization of Rice Straw Fiber and Paper
2.7.1. Morphology of Rice Straw Fiber
2.7.2. Fourier Transform Infrared (FTIR) Spectroscopy
2.7.3. Physical Properties of RSP
2.7.4. Morphology by Scanning Electron Microscopy (SEM)
2.7.5. Water Barrier of RSPs
2.7.6. Antibacterial Activity of Rice Straw Paper
2.8. Statistical Analysis
3. Results and Discussion
3.1. Fiber Morphology and Mechanical Properties of Rice Straw Fibers
3.2. HPLC Analysis and Total Phenolic Content of Longan Peel Extract
3.3. FTIR Spectra of Longan Peel Extract Non-Coated and Coated RSP
3.4. Characterization of Non-Coated and Coated RSP
3.4.1. Physical Properties of Non-Coated and Coated RSP
3.4.2. Water Barrier Properties of Non-Coated and Coated RSP
3.4.3. Scanning Electron Microscopy (SEM) of RSP
3.5. Antibacterial Activity of RSP with and without Longan Peel Extract Coating
4. Conclusions
Author Contributions
Funding
Institutional Review Board Statement
Informed Consent Statement
Data Availability Statement
Acknowledgments
Conflicts of Interest
References
- FAO. Food Outlook—Biannual Report on Global Food Markets, July 2018; FAO: Rome, Italy, 2018; 169p. [Google Scholar]
- Gonzales, M.; Gonzales, V. Sample preparation of tropical and subtropical fruit biowastes to determine antioxidant phytochemicals. Anal. Methods 2015, 2, 1842–1866. [Google Scholar] [CrossRef]
- Rangkadilok, N.; Worasuttayangkurn, L.; Bennett, R.N.; Satayavivad, J. Identification and quantification of polyphenolic compounds in longan (Euphoria longana Lam.) fruit. J. Agric. Food Chem. 2005, 53, 1387–1392. [Google Scholar] [CrossRef]
- Shi, J.; Sun, J.; Wei, X.; Shi, J.; Cheng, G.; Zhao, M.; Jiang, Y. Identification of (−)-epicatechin as the direct substrate for polyphenol oxidase from longan fruit pericarp. LWT-Food Sci. Technol. 2008, 41, 1742–1747. [Google Scholar] [CrossRef]
- Tang, Y.; He, X.; Sun, J.; Li, C.; Li, L.; Sheng, J.; Xin, M.; Li, Z.; Zheng, F.; Liu, G.; et al. Polyphenols and alkaloids in byproducts of longan fruits (Dimocarpus Longan Lour.) and their bioactivities. Molecules 2019, 24, 1186. [Google Scholar] [CrossRef] [Green Version]
- Tanase, C.; Coșarcă, S.; Muntean, D.-L. A Critical Review of Phenolic Compounds Extracted from the Bark of Woody Vascular Plants and Their Potential Biological Activity. Molecules 2019, 24, 1182. [Google Scholar] [CrossRef] [Green Version]
- Kumar, H.; Bhardwaj, K.; Cruz-Martins, N.; Nepovimova, E.; Oleksak, P.; Dhanjal, D.S.; Bhardwaj, S.; Singh, R.; Chopra, C.; Verma, R.; et al. Applications of Fruit Polyphenols and Their Functionalized Nanoparticles Against Foodborne Bacteria: A Mini Review. Molecules 2021, 26, 3447. [Google Scholar] [CrossRef]
- Kaur, D.; Bhardwaj, N.K.; Lohchab, R.K. Prospects of rice straw as a raw material for paper making. Waste Manag. 2017, 60, 127–139. [Google Scholar] [CrossRef]
- Athira, G.; Bahurudeen, A.; Appari, S. Sustainable alternatives to carbon intensive paddy field burning in India: A framework for cleaner production in agriculture, energy, and construction industries. J. Clean. Prod. 2019, 236, e117598. [Google Scholar] [CrossRef]
- Wu, H.; Lei, Y.; Zhu, R.; Zhao, M.; Lu, J.; Xiao, D.; Jiao, C.; Zhang, Z.; Shen, G.; Li, S. Preparation and characterization of bioactive edible packaging films based on pomelo peel flours incorporating tea polyphenol. Food Hydrocoll. 2019, 90, 41–49. [Google Scholar] [CrossRef]
- Benbettaieb, N.; Karbowiak, T.; Debeaufort, F. Bioactive edible films for food applications: Influence of the bioactive compounds on film structure and properties. Cri. Rev. Food Sci. Nutr. 2019, 59, 1137–1153. [Google Scholar] [CrossRef]
- Ramos, M.; Beltran, A.; Fortunati, E.; Peltzer, M.; Cristofaro, F.; Visai, L.; Valente, A.J.M.; Jiménez, A.; Kenny, J.M.; Garrigós, M.C. Controlled Release of Thymol from Poly(Lactic Acid)-Based Silver Nanocomposite Films with Antibacterial and Antioxidant Activity. Antioxidants 2020, 9, 395. [Google Scholar] [CrossRef]
- Wang, Q.; Liu, W.; Tian, B.; Li, D.; Liu, C.; Jiang, B.; Feng, Z. Preparation and Characterization of Coating Based on Protein Nanofibers and Polyphenol and Application for Salted Duck Egg Yolks. Foods 2020, 9, 449. [Google Scholar] [CrossRef] [Green Version]
- Jiang, B.; Na, J.; Wang, L.; Li, D.; Liu, C.; Feng, Z. Reutilization of Food Waste: One-Step Extraction, Purification and Char-acterization of Ovalbumin from Salted Egg White by Aqueous Two-Phase Flotation. Foods 2019, 8, 286. [Google Scholar] [CrossRef] [Green Version]
- Bhardwaj, S.; Bhardwaj, N.K.; Negi, Y.S. Enhancement of processability, surface, and mechanical properties of paper based on rice straw pulp using biopolymers for packaging applications. TAPPI J. 2019, 18, 431–440. [Google Scholar] [CrossRef]
- Zhao, G.; Du, J.; Chen, W.; Pan, M.; Chen, D. Preparation and thermostability of cellulose nanocrystals and nanofibrils from two sources of biomass: Rice straw and poplar wood. Cellulose 2019, 26, 8625–8643. [Google Scholar] [CrossRef]
- Chollakup, R.; Kongtud, W.; Sukatta, U.; Piriyasatits, K.; Premchookiat, M.; Jarerat, A. Development of rice straw paper coated with pomelo peel extract for bio-based and antibacterial packaging. Key Eng. Mater. 2020, 847, 141–146. [Google Scholar] [CrossRef]
- Tseng, H.C.; Wu, W.T.; Huang, H.S.; Wu, M.C. Antimicrobial activities of various fractions of longan (Dimocarpus longan Lour. Fen Ke) seed extract. Int. J. Food Sci. Nutr. 2014, 65, 589–593. [Google Scholar] [CrossRef]
- TAPPI. Standards Brightness of Pulp, Paper, and Paperboard (Directional Reflectance at 457 nm), Test Method; 2018. [Google Scholar]
- TAPPI, Tensile Properties of Paper and Paperboard (Using Constant Rate of Elongation Apparatus), Test Method; 2006.
- Mansour, A.C.G. Rice straw and wheat straw for fine papers. In Proceedings of the TAPPI Pulping Conference, Hollywood, FL, USA, 3–7 November 1985; p. 401. [Google Scholar]
- Hurter, R.W. Nonwood fibres and moulded products. Pap. Technol. 2015, 56, 14–17. [Google Scholar]
- Chen, C.; Yu, J.; Zhang, Z.; Lu, C. Study on structure and thermal stability properties of cellulose fibres from rice straw. Carbohydr. Polym. 2011, 85, 245–250. [Google Scholar] [CrossRef]
- Ona, T.; Sonoda, T.; Ito, K.; Shibata, M.; Tamai, Y.; Kojima, Y.; Ohshima, J.; Yokota, S.; Yoshizawa, N. Investigation of relationship between cell and pulp properties in Eucalyptus by examination of within-tree property variations. Wood Sci. Technol. 2001, 35, 229–243. [Google Scholar] [CrossRef]
- Kiaei, M.; Tajik, M.; Vaysi, V. Chemical and biometrical properties of plum wood and its application in pulp and paper production. Maderas-Cienc. Technol. 2014, 16, 313–322. [Google Scholar] [CrossRef] [Green Version]
- Dinwoodie, J.M. The relationship between fiber morphology and paper properties: A review of literature. TAPPI J. 1965, 48, 440–447. [Google Scholar]
- Jaitrong, S.; Rattanapanone, N.; Manthey, J.A. Analysis of the phenolic compounds in longan (Dimocarpus Longan Lour.) peel. Proc. Fla. State Hortic. Soc. 2006, 119, 371–375. [Google Scholar]
- Ibrahim, M.M.; El-Zawawy, W.K.; Abdel-Fattah, Y.R.; Soliman, N.A.; Agblevor, F.A. Comparison of alkaline pulping with steam explosion for glucose production from rice straw. Carbohydr. Polym. 2011, 83, 720–726. [Google Scholar] [CrossRef]
- Vaithanomsat, P.; Kongsin, K.; Trakunjae, C.; Boonyarit, J.; Jarerat, A.; Sudesh, K.; Chollakup, R. Biosynthesized Poly(3-Hydroxybutyrate) on Coated Pineapple Leaf Fiber Papers for Biodegradable Packaging Application. Polymers 2021, 13, 1733. [Google Scholar] [CrossRef]
- Rudi, H.; Resalati, H.; Eshkiki, R.B.; Kermanian, H. Sunflower Stalk Neutral Sulfite Semi-Chemical Pulp: An Alternative Fiber Source for Production of Fluting Paper. J. Clean. Prod. 2016, 127, 562–566. [Google Scholar] [CrossRef]
- Pereira, D.M.; Valentão, P.; Pereira, J.A.; Andrade, P.B. Phenolics: From chemistry to biology. Molecules 2009, 14, 2202–2211. [Google Scholar] [CrossRef]
- Rodriguez, A.; Batlle, R.; Nerin, C. The use of natural essential oils as antimicrobial solutions in paper packaging. Part II. Prog. Org. Coat. 2007, 60, 33–38. [Google Scholar] [CrossRef]
- Yan, H.; Du, Z.; Ma, S.; Cheng, S.; Jiang, S.; Liu, Y.; Li, D.; Huang, H.; Zhang, K.; Zheng, X. Biosynthesis, antibacterial activity and anticancer effects against prostate cancer (PC-3) cells of silver nanoparticles using Dimocarpus Longan Lour. peel extract. Nanoscale Res. Lett. 2016, 11, e300. [Google Scholar]
- Phongtongpasuk, S.; Poadang, S.; Yongvanich, N. Green synthetic approach to prepare silver nanoparticles using longan (Dimocarpus longan) peel extract and evaluation of their antibacterial activities. Mater. Today Proc. 2017, 4, 6317–6325. [Google Scholar] [CrossRef]
- Nguyen, A.T.; Tallent, S.M. Screening food for Bacillus cereus toxins using whole genome sequencing. Food Microbiol. 2019, 78, 164–170. [Google Scholar] [CrossRef] [PubMed]
- Li, H.; Tang, T.; Stegger, M.; Dalsgaard, A.; Liu, T.; Leisner, J.J. Characterization of antimicrobial-resistant Staphylococcus aureus from retail foods in Beijing, China. Food Microbiol. 2021, 93, e103603. [Google Scholar] [CrossRef]

| Sample | Fiber Morphology | Mechanical Properties | |||||
|---|---|---|---|---|---|---|---|
| This Study | Reference [17] | This Study | Reference [17] | ||||
| Cell Wall Thickness (μm) | Fiber Length (μm) | Fiber Width (μm) | Lumen Width (μm) | Runkel Ratio | Flexibility Coefficient | Felting Coefficient | |
| Rice straw fiber | 1.5 ± 0.1 | 800 ± 410 | 10.2 ± 5.3 | 8.7 ± 0.4 | 0.34 ± 0.01 | 0.85 ± 0.04 | 78.43 ± 4.12 |
| Properties | Non-Coated RSP [17] | Starch Coated RSP | Coated RSP with Longan Peel Extract (w/v) | ||
|---|---|---|---|---|---|
| 10% | 15% | 20% | |||
| Basis weight (g/m2) | 106.42 ± 6.08 b | 118.19 ± 5.93 a | 118.20 ± 9.44 a | 117.03 ± 9.95 a | 118.95 ± 3.32 a |
| Thickness (mm) | 0.34 ± 0.01 c | 0.44 ± 0.06 a | 0.38 ± 0.01 b | 0.39 ± 0.07 b | 0.38 ± 0.02 b |
| Brightness (%) | 34.15 ± 0.49 a | 32.76 ± 1.64 a | 22.74 ± 1.39 b | 20.76 ± 0.85 c | 16.05 ± 0.62 d |
| Tensile index (N·m/g) | 32.26 ± 4.36 b | 33.05 ± 4.92 b | 32.98 ± 5.78 b | 32.67 ± 3.15 b | 36.20 ± 2.75 a |
| Bacteria Test | Diameter of Inhibition Zone (mm) 1 | |||||
|---|---|---|---|---|---|---|
| Non-Coated RSP | RSP with Longan Peel Extract (w/v) | Positive Control 2 [17] | ||||
| 10% | 15% | 20% | Penicillin G | Streptomycin | ||
| S. aureus ATCC 6538 | - | 12.57 ± 1.00 d | 14.36 ± 0.37 c | 14.47 ± 1.47 c | 43.20 ± 2.02 a | 18.50 ± 0.50 b |
| B. cereus ATCC 11778 | - | 10.37 ± 1.01 a | 11.10 ± 0.62 a | 10.77 ± 0.63 a | 11.50 ± 0.50 a | - |
| E. coli ATCC 25922 | - | - | - | - | 8.00 ± 0.50 b | 23.00 ± 0.87 a |
Publisher’s Note: MDPI stays neutral with regard to jurisdictional claims in published maps and institutional affiliations. |
© 2021 by the authors. Licensee MDPI, Basel, Switzerland. This article is an open access article distributed under the terms and conditions of the Creative Commons Attribution (CC BY) license (https://creativecommons.org/licenses/by/4.0/).
Share and Cite
Chollakup, R.; Kongtud, W.; Sukatta, U.; Premchookiat, M.; Piriyasatits, K.; Nimitkeatkai, H.; Jarerat, A. Eco-Friendly Rice Straw Paper Coated with Longan (Dimocarpus longan) Peel Extract as Bio-Based and Antibacterial Packaging. Polymers 2021, 13, 3096. https://doi.org/10.3390/polym13183096
Chollakup R, Kongtud W, Sukatta U, Premchookiat M, Piriyasatits K, Nimitkeatkai H, Jarerat A. Eco-Friendly Rice Straw Paper Coated with Longan (Dimocarpus longan) Peel Extract as Bio-Based and Antibacterial Packaging. Polymers. 2021; 13(18):3096. https://doi.org/10.3390/polym13183096
Chicago/Turabian StyleChollakup, Rungsima, Wuttinant Kongtud, Udomlak Sukatta, Maneenuch Premchookiat, Kanyanut Piriyasatits, Hataitip Nimitkeatkai, and Amnat Jarerat. 2021. "Eco-Friendly Rice Straw Paper Coated with Longan (Dimocarpus longan) Peel Extract as Bio-Based and Antibacterial Packaging" Polymers 13, no. 18: 3096. https://doi.org/10.3390/polym13183096
APA StyleChollakup, R., Kongtud, W., Sukatta, U., Premchookiat, M., Piriyasatits, K., Nimitkeatkai, H., & Jarerat, A. (2021). Eco-Friendly Rice Straw Paper Coated with Longan (Dimocarpus longan) Peel Extract as Bio-Based and Antibacterial Packaging. Polymers, 13(18), 3096. https://doi.org/10.3390/polym13183096

